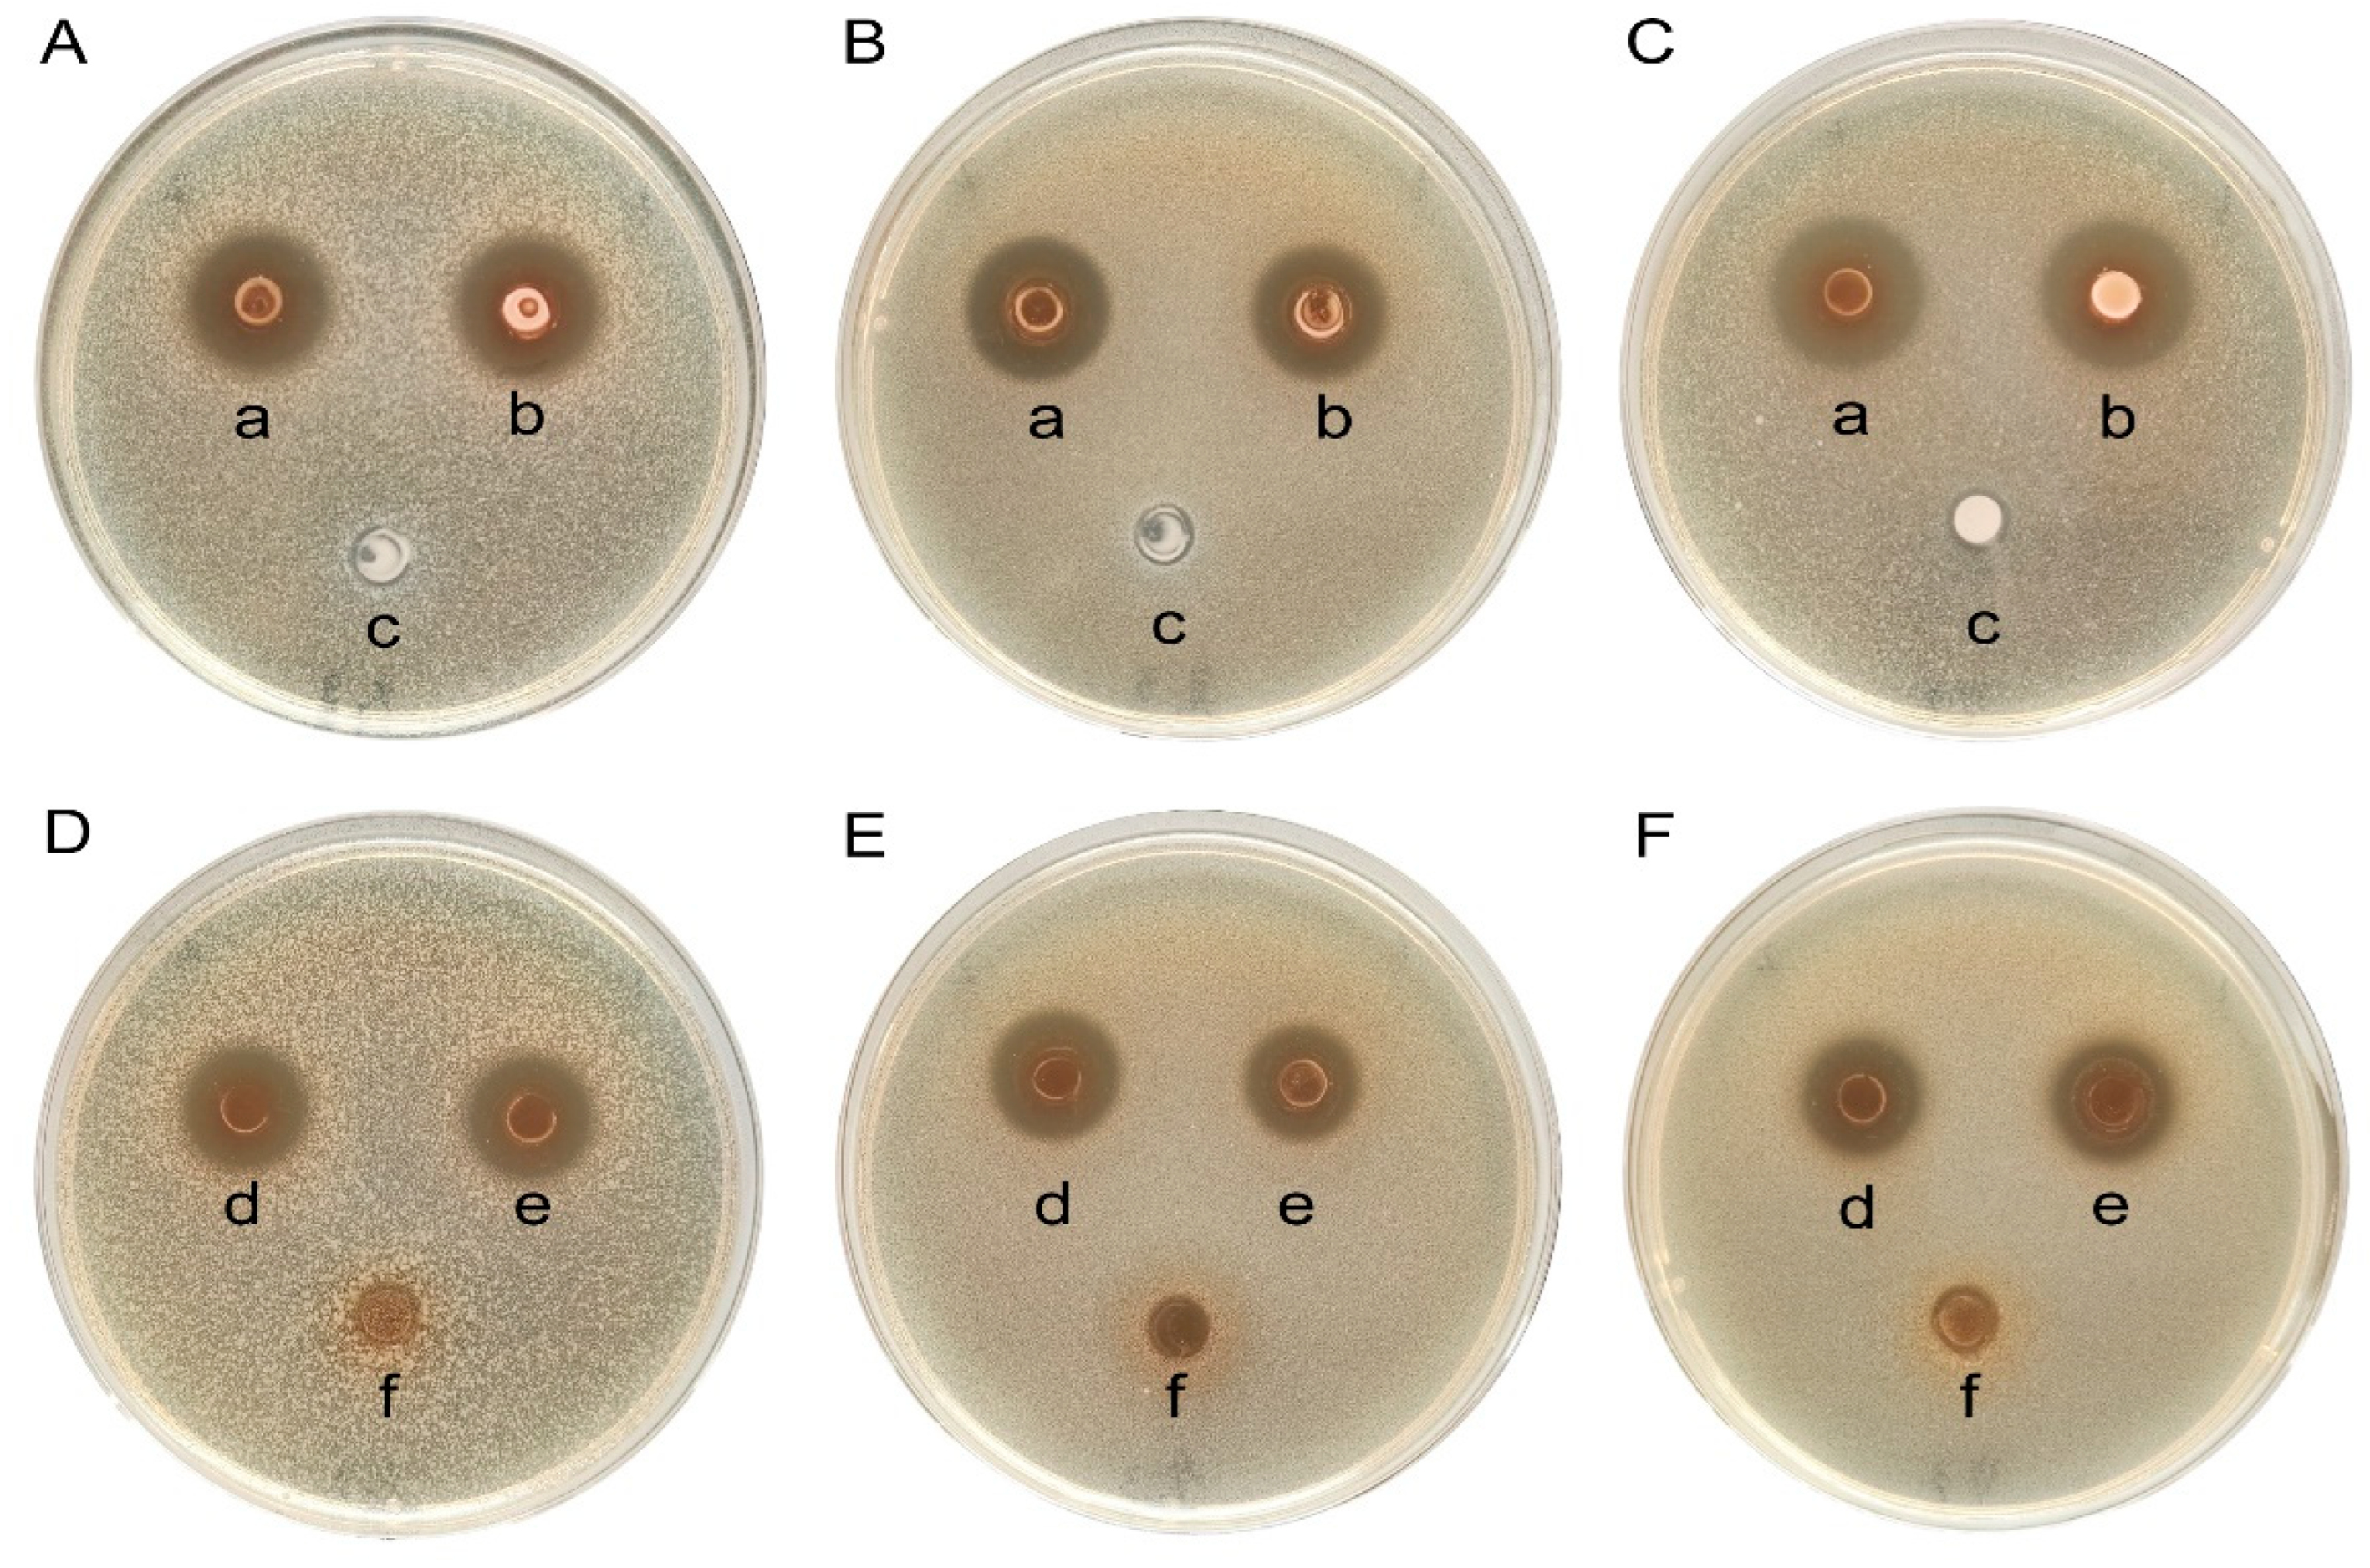
Microorganisms 12 01811 g005

Potential Probiotic Properties and Complete Genome Analysis of Limosilactobacillus reuteri LRA7 from Dogs
Abstract
1. Introduction
2. Materials and Methods
2.1. Bacterial Characteristics
2.1.1. Isolation and Culture of Strains
2.1.2. Identification of Strains
2.2. In Vitro Studies
2.2.1. First-Level Screening of Strains: Antimicrobial Activity
2.2.2. Secondary Screening of Strains: Antioxidant Activity
Cell-Free Supernatant Preparation
1,1-Diphenyl-2-Picryl-Hydrazyl (DPPH) Scavenging Capacity
2,2′-Azinobis-(3-Ethylbenzthiazoline-6-Sulphonate) (ABTS) Scavenging Capacity
Superoxide Anion (O2−) Scavenging Capacity
2.2.3. Tertiary Screening of Strains: Acid Tolerance
2.2.4. Growth and Acid Production Capacity of Strain LRA7
2.2.5. Gastrointestinal Tract Tolerance of Strain LRA7
2.2.6. Surface Hydrophilicity of Strain LRA7
2.2.7. Auto-Aggregation Capacity of Strain LRA7
2.2.8. High-Temperature Resistance of Strain LRA7
2.2.9. Characterization of Antimicrobial Substances of Strain LRA7
2.2.10. Antibiotic Sensitivity of Strain LRA7
2.2.11. Hemolytic Activity of Strain LRA7
2.3. In Vivo Studies
2.3.1. Test Animals and Management
2.3.2. Sample Collection
2.4. Genome Analysis
2.5. Statistical Analysis
3. Results
3.1. LAB Isolation and Characterization
3.2. In Vitro Results
3.2.1. Strain Screening
3.2.2. Morphological Characteristics of Strain LRA7
3.2.3. Growth Characteristics of Strain LRA7
3.2.4. Analysis of Gastrointestinal Tolerance
3.2.5. Hydrophobicity and Self-Coalescence Analysis
3.2.6. High-Temperature Tolerance Analysis
3.2.7. Characterization of Bacteriostatic Substances
3.2.8. Antibiotic Sensitivity
3.2.9. Hemolytic Activity
3.3. In Vivo Safety Assessment in Mice
3.4. Analysis of the Complete Genome of L. reuteri LRA7
3.4.1. General Characterization of the Genome of Strain LRA7
3.4.2. Functional Annotation of Strain LRA7 Genome
4. Discussion
5. Conclusions
Supplementary Materials
Author Contributions
Funding
Institutional Review Board Statement
Informed Consent Statement
Data Availability Statement
Acknowledgments
Conflicts of Interest
Abbreviations
| LAB | Lactic acid bacteria |
| CFS | cell-free supernatant |
| DPPH | 1,1-diphenyl-2-picryl-hydrazyl |
| MRS | Man, Rogosa, and Sharpe |
| OD | optical density |
| ABTS | 2,2′-Azinobis-(3-ethylbenzthiazoline-6-sulphonate) |
| O2− | superoxide anion |
| TSB | Tryptic Soy Broth |
| TSA | Tryptone Soy Agar |
| GO | Gene Ontology |
| COG | Cluster of Orthologous Groups of proteins |
| VFDB | virulence Factors Database |
| KEGG | Kyoto Encyclopedia of Genes and Genomes |
| CAZy | Carbohydrate-Active enZYmes Database |
| TCDB | Transporter Classification Database |
| Nr | Non-Redundant Protein Database |
| CARD | Comprehensive Antibiotic Research Database |
| V/C | villus length/crypt depth |
| AST | aspartate aminotransferase |
| ALT | alanine aminotransferase |
| SOD | superoxide dismutase |
| MDA | malondialdehyde |
| T-AOC | total antioxidant capacity |
| G + C | Guanine + Cytosine |
References
- Hill, C.; Guarner, F.; Reid, G.; Gibson, G.R.; Merenstein, D.J.; Pot, B.; Morelli, L.; Canani, R.B.; Flint, H.J.; Salminen, S.; et al. Expert Consensus Document. The International Scientific Association for Probiotics and Prebiotics Consensus Statement on the Scope and Appropriate Use of the Term Probiotic. Nat. Rev. Gastroenterol. Hepatol. 2014, 11, 506–514. [Google Scholar] [CrossRef]
- Qi, C.; Sun, J.; Li, Y.; Gu, M.; Goulette, T.; You, X.; Sela, D.A.; Wang, X.; Xiao, H. Peyer’s Patch-Specific Lactobacillus reuteri Strains Increase Extracellular Microbial DNA and Antimicrobial Peptide Expression in the Mouse Small Intestine. Food Funct. 2018, 9, 2989–2997. [Google Scholar] [CrossRef] [PubMed]
- Özogul, F.; Hamed, I. The Importance of Lactic Acid Bacteria for the Prevention of Bacterial Growth and Their Biogenic Amines Formation: A Review. Crit. Rev. Food Sci. Nutr. 2018, 58, 1660–1670. [Google Scholar] [CrossRef] [PubMed]
- Ahmad, W.; Nasir, A.; Sattar, F.; Ashfaq, I.; Chen, M.-H.; Hayat, A.; Rehman, M.U.; Zhao, S.; Khaliq, S.; Ghauri, M.A.; et al. Production of Bimodal Molecular Weight Levan by a Lactobacillus reuteri Isolate from Fish Gut. Folia Microbiol. 2022, 67, 21–31. [Google Scholar] [CrossRef] [PubMed]
- Cotter, P.D.; Ross, R.P.; Hill, C. Bacteriocins—A Viable Alternative to Antibiotics? Nat. Rev. Microbiol. 2013, 11, 95–105. [Google Scholar] [CrossRef] [PubMed]
- Mao, A.; Chen, X.; Zhao, W.; Nan, W.; Huang, Y.; Sun, Y.; Zhang, H.; Xu, C. Bacterial Community Influences the Effects of Lactobacillus Acidophilus on Lipid Metabolism, Immune Response, and Antioxidant Capacity in Dogs. Animals 2024, 14, 1257. [Google Scholar] [CrossRef]
- Wang, L.; Zhang, Z.; Zhu, X.; Zhao, Y.; Iqbal, M.; Lin, Z.; Nawaz, S.; Xu, M.; Hu, M.; Bhutto, Z.A.; et al. The Effect of Lactobacillus Sakei on Growth Performance and Intestinal Health in Dogs: Gut Microbiota and Metabolism Study. Probiotics Antimicrob. Proteins 2023. Epub ahead of print. [Google Scholar] [CrossRef]
- Gómez-Gallego, C.; Junnila, J.; Männikkö, S.; Hämeenoja, P.; Valtonen, E.; Salminen, S.; Beasley, S. A Canine-Specific Probiotic Product in Treating Acute or Intermittent Diarrhea in Dogs: A Double-Blind Placebo-Controlled Efficacy Study. Vet. Microbiol. 2016, 197, 122–128. [Google Scholar] [CrossRef]
- Montgomery, T.L.; Eckstrom, K.; Lile, K.H.; Caldwell, S.; Heney, E.R.; Lahue, K.G.; D’Alessandro, A.; Wargo, M.J.; Krementsov, D.N. Lactobacillus reuteri Tryptophan Metabolism Promotes Host Susceptibility to CNS Autoimmunity. Microbiome 2022, 10, 198. [Google Scholar] [CrossRef]
- Bender, M.J.; McPherson, A.C.; Phelps, C.M.; Pandey, S.P.; Laughlin, C.R.; Shapira, J.H.; Medina Sanchez, L.; Rana, M.; Richie, T.G.; Mims, T.S.; et al. Dietary Tryptophan Metabolite Released by Intratumoral Lactobacillus reuteri Facilitates Immune Checkpoint Inhibitor Treatment. Cell 2023, 186, 1846–1862.e26. [Google Scholar] [CrossRef]
- Lin, Z.; Wu, J.; Wang, J.; Levesque, C.L.; Ma, X. Dietary Lactobacillus reuteri Prevent from Inflammation Mediated Apoptosis of Liver via Improving Intestinal Microbiota and Bile Acid Metabolism. Food Chem. 2023, 404, 134643. [Google Scholar] [CrossRef]
- Yi, H.; Wang, L.; Xiong, Y.; Wen, X.; Wang, Z.; Yang, X.; Gao, K.; Jiang, Z. Effects of Lactobacillus reuteri LR1 on the Growth Performance, Intestinal Morphology, and Intestinal Barrier Function in Weaned Pigs. J. Anim. Sci. 2018, 96, 2342–2351. [Google Scholar] [CrossRef] [PubMed]
- Chai, C.; Guo, Y.; Mohamed, T.; Bumbie, G.Z.; Wang, Y.; Zeng, X.; Zhao, J.; Du, H.; Tang, Z.; Xu, Y.; et al. Dietary Lactobacillus reuteri SL001 Improves Growth Performance, Health-Related Parameters, Intestinal Morphology and Microbiota of Broiler Chickens. Animals 2023, 13, 1690. [Google Scholar] [CrossRef] [PubMed]
- de Godoy, M.R.C.; Hervera, M.; Swanson, K.S.; Fahey, G.C. Innovations in Canine and Feline Nutrition: Technologies for Food and Nutrition Assessment. Annu. Rev. Anim. Biosci. 2016, 4, 311–333. [Google Scholar] [CrossRef]
- Plessas, S.; Nouska, C.; Karapetsas, A.; Kazakos, S.; Alexopoulos, A.; Mantzourani, I.; Chondrou, P.; Fournomiti, M.; Galanis, A.; Bezirtzoglou, E. Isolation, Characterization and Evaluation of the Probiotic Potential of a Novel Lactobacillus Strain Isolated from Feta-Type Cheese. Food Chem. 2017, 226, 102–108. [Google Scholar] [CrossRef] [PubMed]
- Shi, Y.; Zhao, J.; Kellingray, L.; Zhang, H.; Narbad, A.; Zhai, Q.; Chen, W. In Vitro and in Vivo Evaluation of Lactobacillus Strains and Comparative Genomic Analysis of Lactobacillus Plantarum CGMCC12436 Reveal Candidates of Colonise-Related Genes. Food Res. Int. 2019, 119, 813–821. [Google Scholar] [CrossRef]
- Chen, T.; Wang, L.; Li, Q.; Long, Y.; Lin, Y.; Yin, J.; Zeng, Y.; Huang, L.; Yao, T.; Abbasi, M.N.; et al. Functional Probiotics of Lactic Acid Bacteria from Hu Sheep Milk. BMC Microbiol. 2020, 20, 228. [Google Scholar] [CrossRef]
- Simpson, P.J.; Stanton, C.; Fitzgerald, G.F.; Ross, R.P. Intrinsic Tolerance of Bifidobacterium Species to Heat and Oxygen and Survival Following Spray Drying and Storage. J. Appl. Microbiol. 2005, 99, 493–501. [Google Scholar] [CrossRef]
- Martins, E.; Cnossen, D.C.; Silva, C.R.J.; Cezarino, J.C.; Nero, L.A.; Perrone, I.T.; Carvalho, A.F. Determination of Ideal Water Activity and Powder Temperature after Spray Drying to Reduce Lactococcus Lactis Cell Viability Loss. J. Dairy Sci. 2019, 102, 6013–6022. [Google Scholar] [CrossRef]
- De Angelis, M.; Siragusa, S.; Berloco, M.; Caputo, L.; Settanni, L.; Alfonsi, G.; Amerio, M.; Grandi, A.; Ragni, A.; Gobbetti, M. Selection of Potential Probiotic Lactobacilli from Pig Feces to Be Used as Additives in Pelleted Feeding. Res. Microbiol. 2006, 157, 792–801. [Google Scholar] [CrossRef]
- Ahmad, W.; Khaliq, S.; Akhtar, N.; El Arab, J.; Akhtar, K.; Prakash, S.; Anwar, M.A.; Munawar, N. Whole Genome Sequence Analysis of a Novel Apilactobacillus Species from Giant Honeybee (Apis dorsata) Gut Reveals Occurrence of Genetic Elements Coding Prebiotic and Probiotic Traits. Microorganisms 2022, 10, 904. [Google Scholar] [CrossRef] [PubMed]
- Peng, X.; Ed-Dra, A.; Yue, M. Whole Genome Sequencing for the Risk Assessment of Probiotic Lactic Acid Bacteria. Crit. Rev. Food Sci. Nutr. 2023, 63, 11244–11262. [Google Scholar] [CrossRef] [PubMed]
- Coulibaly, W.H.; Kouadio, N.R.; Camara, F.; Diguță, C.; Matei, F. Functional Properties of Lactic Acid Bacteria Isolated from Tilapia (Oreochromis niloticus) in Ivory Coast. BMC Microbiol. 2023, 23, 152. [Google Scholar] [CrossRef]
- Kumar, S.; Pattanaik, A.K.; Sharma, S.; Jadhav, S.E.; Dutta, N.; Kumar, A. Probiotic Potential of a Lactobacillus Bacterium of Canine Faecal-Origin and Its Impact on Select Gut Health Indices and Immune Response of Dogs. Probiotics Antimicrob. Proteins 2017, 9, 262–277. [Google Scholar] [CrossRef]
- Liu, Z.; Xu, C.; Tian, R.; Wang, W.; Ma, J.; Gu, L.; Liu, F.; Jiang, Z.; Hou, J. Screening Beneficial Bacteriostatic Lactic Acid Bacteria in the Intestine and Studies of Bacteriostatic Substances. J. Zhejiang Univ. Sci. B 2021, 22, 533–547. [Google Scholar] [CrossRef]
- Jomehzadeh, N.; Javaherizadeh, H.; Amin, M.; Saki, M.; Al-Ouqaili, M.T.; Hamidi, H.; Seyedmahmoudi, M.; Gorjian, Z. Isolation and Identification of Potential Probiotic Lactobacillus Species from Feces of Infants in Southwest Iran. Int. J. Infect. Dis. 2020, 96, 524–530. [Google Scholar] [CrossRef] [PubMed]
- Zhang, C.; Xia, S.; Zhang, Y.; Zhu, S.; Li, H.; Liu, X. Identification of Soybean Peptides and Their Effect on the Growth and Metabolism of Limosilactobacillus reuteri LR08. Food Chem. 2022, 369, 130923. [Google Scholar] [CrossRef] [PubMed]
- Feng, C.; Zhang, F.; Wang, B.; Zhang, L.; Dong, Y.; Shao, Y. Genome-Wide Analysis of Fermentation and Probiotic Trait Stability in Lactobacillus Plantarum during Continuous Culture. J. Dairy Sci. 2020, 103, 117–127. [Google Scholar] [CrossRef]
- Ma, K.; Chen, W.; Lin, X.-Q.; Liu, Z.-Z.; Wang, T.; Zhang, J.-B.; Zhang, J.-G.; Zhou, C.-K.; Gao, Y.; Du, C.-T.; et al. Culturing the Chicken Intestinal Microbiota and Potential Application as Probiotics Development. Int. J. Mol. Sci. 2023, 24, 3045. [Google Scholar] [CrossRef]
- Min, B.; Yoo, D.; Lee, Y.; Seo, M.; Kim, H. Complete Genomic Analysis of Enterococcus Faecium Heat-Resistant Strain Developed by Two-Step Adaptation Laboratory Evolution Method. Front. Bioeng. Biotechnol. 2020, 8, 828. [Google Scholar] [CrossRef]
- Prabhurajeshwar, C.; Chandrakanth, R.K. Probiotic Potential of Lactobacilli with Antagonistic Activity against Pathogenic Strains: An in Vitro Validation for the Production of Inhibitory Substances. Biomed. J. 2017, 40, 270–283. [Google Scholar] [CrossRef] [PubMed]
- Ahire, J.J.; Jakkamsetty, C.; Kashikar, M.S.; Lakshmi, S.G.; Madempudi, R.S. In Vitro Evaluation of Probiotic Properties of Lactobacillus Plantarum UBLP40 Isolated from Traditional Indigenous Fermented Food. Probiotics Antimicrob. Proteins 2021, 13, 1413–1424. [Google Scholar] [CrossRef] [PubMed]
- Zhang, W.; Lai, S.; Zhou, Z.; Yang, J.; Liu, H.; Zhong, Z.; Fu, H.; Ren, Z.; Shen, L.; Cao, S.; et al. Screening and Evaluation of Lactic Acid Bacteria with Probiotic Potential from Local Holstein Raw Milk. Front. Microbiol. 2022, 13, 918774. [Google Scholar] [CrossRef] [PubMed]
- Li, A.; Wang, Y.; Li, Z.; Qamar, H.; Mehmood, K.; Zhang, L.; Liu, J.; Zhang, H.; Li, J. Probiotics Isolated from Yaks Improves the Growth Performance, Antioxidant Activity, and Cytokines Related to Immunity and Inflammation in Mice. Microb. Cell Fact. 2019, 18, 112. [Google Scholar] [CrossRef] [PubMed]
- He, L.; Zhou, X.; Liu, Y.; Zhou, L.; Li, F. Fecal miR-142a-3p from Dextran Sulfate Sodium-Challenge Recovered Mice Prevents Colitis by Promoting the Growth of Lactobacillus reuteri. Mol. Ther. 2022, 30, 388–399. [Google Scholar] [CrossRef]
- Kong, Q.; Shang, Z.; Nawaz, S.; Liu, S.; Li, J. The Whole-Genome Sequencing and Probiotic Profiling of Lactobacillus reuteri Strain TPC32 Isolated from Tibetan Pig. Nutrients 2024, 16, 1900. [Google Scholar] [CrossRef]
- Seemann, T. Prokka: Rapid Prokaryotic Genome Annotation. Bioinformatics 2014, 30, 2068–2069. [Google Scholar] [CrossRef]
- UniProt: The Universal Protein Knowledgebase in 2021. Nucleic Acids Res. 2020, 49, D480–D489. [CrossRef]
- Ashburner, M.; Ball, C.A.; Blake, J.A.; Botstein, D.; Butler, H.; Cherry, J.M.; Davis, A.P.; Dolinski, K.; Dwight, S.S.; Eppig, J.T.; et al. Gene Ontology: Tool for the Unification of Biology. Nat. Genet. 2000, 25, 25–29. [Google Scholar] [CrossRef]
- Tatusov, R.L.; Galperin, M.Y.; Natale, D.A.; Koonin, E.V. The COG Database: A Tool for Genome-Scale Analysis of Protein Functions and Evolution. Nucleic Acids Res. 2000, 28, 33–36. [Google Scholar] [CrossRef]
- Kanehisa, M.; Goto, S.; Kawashima, S.; Okuno, Y.; Hattori, M. The KEGG Resource for Deciphering the Genome. Nucleic Acids Res. 2004, 32, D277–D280. [Google Scholar] [CrossRef] [PubMed]
- Winnenburg, R.; Baldwin, T.K.; Urban, M.; Rawlings, C.; Köhler, J.; Hammond-Kosack, K.E. PHI-Base: A New Database for Pathogen Host Interactions. Nucleic Acids Res. 2006, 34, D459–D464. [Google Scholar] [CrossRef]
- Saier, M.H.; Tran, C.V.; Barabote, R.D. TCDB: The Transporter Classification Database for Membrane Transport Protein Analyses and Information. Nucleic Acids Res. 2006, 34, D181–D186. [Google Scholar] [CrossRef] [PubMed]
- Alcock, B.P.; Raphenya, A.R.; Lau, T.T.Y.; Tsang, K.K.; Bouchard, M.; Edalatmand, A.; Huynh, W.; Nguyen, A.-L.V.; Cheng, A.A.; Liu, S.; et al. CARD 2020: Antibiotic Resistome Surveillance with the Comprehensive Antibiotic Resistance Database. Nucleic Acids Res. 2020, 48, D517–D525. [Google Scholar] [CrossRef]
- Sabio, L.; González, A.; Ramírez-Rodríguez, G.B.; Gutiérrez-Fernández, J.; Bañuelo, O.; Olivares, M.; Gálvez, N.; Delgado-López, J.M.; Dominguez-Vera, J.M. Probiotic Cellulose: Antibiotic-Free Biomaterials with Enhanced Antibacterial Activity. Acta Biomater. 2021, 124, 244–253. [Google Scholar] [CrossRef] [PubMed]
- Jose, N.M.; Bunt, C.R.; Hussain, M.A. Comparison of Microbiological and Probiotic Characteristics of Lactobacilli Isolates from Dairy Food Products and Animal Rumen Contents. Microorganisms 2015, 3, 198–212. [Google Scholar] [CrossRef] [PubMed]
- Reuben, R.C.; Roy, P.C.; Sarkar, S.L.; Rubayet Ul Alam, A.S.M.; Jahid, I.K. Characterization and Evaluation of Lactic Acid Bacteria from Indigenous Raw Milk for Potential Probiotic Properties. J. Dairy Sci. 2020, 103, 1223–1237. [Google Scholar] [CrossRef]
- Liguori, I.; Russo, G.; Curcio, F.; Bulli, G.; Aran, L.; Della-Morte, D.; Gargiulo, G.; Testa, G.; Cacciatore, F.; Bonaduce, D.; et al. Oxidative Stress, Aging, and Diseases. Clin. Interv. Aging 2018, 13, 757–772. [Google Scholar] [CrossRef]
- Li, Y.; Hou, S.; Peng, W.; Lin, Q.; Chen, F.; Yang, L.; Li, F.; Huang, X. Oral Administration of Lactobacillus Delbrueckii during the Suckling Phase Improves Antioxidant Activities and Immune Responses after the Weaning Event in a Piglet Model. Oxid. Med. Cell Longev. 2019, 2019, 6919803. [Google Scholar] [CrossRef]
- Ali, M.S.; Lee, E.-B.; Lim, S.-K.; Suk, K.; Park, S.-C. Isolation and Identification of Limosilactobacillus reuteri PSC102 and Evaluation of Its Potential Probiotic, Antioxidant, and Antibacterial Properties. Antioxidants 2023, 12, 238. [Google Scholar] [CrossRef]
- Wang, Y.; Wu, Y.; Wang, Y.; Xu, H.; Mei, X.; Yu, D.; Wang, Y.; Li, W. Antioxidant Properties of Probiotic Bacteria. Nutrients 2017, 9, 521. [Google Scholar] [CrossRef] [PubMed]
- Yang, E.; Fan, L.; Yan, J.; Jiang, Y.; Doucette, C.; Fillmore, S.; Walker, B. Influence of Culture Media, pH and Temperature on Growth and Bacteriocin Production of Bacteriocinogenic Lactic Acid Bacteria. AMB Express 2018, 8, 10. [Google Scholar] [CrossRef] [PubMed]
- Reuben, R.C.; Roy, P.C.; Sarkar, S.L.; Alam, R.-U.; Jahid, I.K. Isolation, Characterization, and Assessment of Lactic Acid Bacteria toward Their Selection as Poultry Probiotics. BMC Microbiol. 2019, 19, 253. [Google Scholar] [CrossRef] [PubMed]
- Shi, S.; Dong, J.; Cheng, X.; Hu, J.; Liu, Y.; He, G.; Zhang, J.; Yu, H.; Jia, L.; Zhou, D. Biological Characteristics and Whole-Genome Analysis of the Potential Probiotic, Lactobacillus reuteri S5. Lett. Appl. Microbiol. 2022, 74, 593–603. [Google Scholar] [CrossRef] [PubMed]
- Xu, H.; Wu, L.; Pan, D.; Zeng, X.; Cai, Z.; Guo, Y.; Wang, W.; Wu, Z. Adhesion Characteristics and Dual Transcriptomic and Proteomic Analysis of Lactobacillus reuteri SH23 upon Gastrointestinal Fluid Stress. J. Proteome Res. 2021, 20, 2447–2457. [Google Scholar] [CrossRef]
- Chaffanel, F.; Charron-Bourgoin, F.; Soligot, C.; Kebouchi, M.; Bertin, S.; Payot, S.; Le Roux, Y.; Leblond-Bourget, N. Surface Proteins Involved in the Adhesion of Streptococcus Salivarius to Human Intestinal Epithelial Cells. Appl. Microbiol. Biotechnol. 2018, 102, 2851–2865. [Google Scholar] [CrossRef]
- Zhou, J.S.; Pillidge, C.J.; Gopal, P.K.; Gill, H.S. Antibiotic Susceptibility Profiles of New Probiotic Lactobacillus and Bifidobacterium Strains. Int. J. Food Microbiol. 2005, 98, 211–217. [Google Scholar] [CrossRef]
- Jaimee, G.; Halami, P.M. Emerging Resistance to Aminoglycosides in Lactic Acid Bacteria of Food Origin-an Impending Menace. Appl. Microbiol. Biotechnol. 2016, 100, 1137–1151. [Google Scholar] [CrossRef]
- De Jesus, L.C.L.; de Jesus Sousa, T.; Coelho-Rocha, N.D.; Profeta, R.; Barroso, F.A.L.; Drumond, M.M.; Mancha-Agresti, P.; Ferreira, Ê.; Brenig, B.; Aburjaile, F.F.; et al. Safety Evaluation of Lactobacillus delbrueckii Subsp. lactis CIDCA 133: A Health-Promoting Bacteria. Probiotics Antimicro. Prot. 2022, 14, 816–829. [Google Scholar] [CrossRef]
- Chen, B.; Zhou, Y.; Duan, L.; Gong, X.; Liu, X.; Pan, K.; Zeng, D.; Ni, X.; Zeng, Y. Complete Genome Analysis of Bacillus Velezensis TS5 and Its Potential as a Probiotic Strain in Mice. Front. Microbiol. 2023, 14, 1322910. [Google Scholar] [CrossRef]
- Greppi, A.; Asare, P.T.; Schwab, C.; Zemp, N.; Stephan, R.; Lacroix, C. Isolation and Comparative Genomic Analysis of Reuterin-Producing Lactobacillus reuteri from the Chicken Gastrointestinal Tract. Front. Microbiol. 2020, 11, 1166. [Google Scholar] [CrossRef] [PubMed]
- Gustaw, K.; Koper, P.; Polak-Berecka, M.; Rachwał, K.; Skrzypczak, K.; Waśko, A. Genome and Pangenome Analysis of Lactobacillus Hilgardii FLUB—A New Strain Isolated from Mead. Int. J. Mol. Sci. 2021, 22, 3780. [Google Scholar] [CrossRef] [PubMed]
- Morita, H.; Toh, H.; Fukuda, S.; Horikawa, H.; Oshima, K.; Suzuki, T.; Murakami, M.; Hisamatsu, S.; Kato, Y.; Takizawa, T.; et al. Comparative Genome Analysis of Lactobacillus reuteri and Lactobacillus Fermentum Reveal a Genomic Island for Reuterin and Cobalamin Production. DNA Res. 2008, 15, 151–161. [Google Scholar] [CrossRef] [PubMed]
- Chen, L.; Gu, Q.; Li, P.; Chen, S.; Li, Y. Genomic Analysis of Lactobacillus reuteri WHH1689 Reveals Its Probiotic Properties and Stress Resistance. Food Sci. Nutr. 2019, 7, 844–857. [Google Scholar] [CrossRef]
- Terzić-Vidojević, A.; Veljović, K.; Popović, N.; Tolinački, M.; Golić, N. Enterococci from Raw-Milk Cheeses: Current Knowledge on Safety, Technological, and Probiotic Concerns. Foods 2021, 10, 2753. [Google Scholar] [CrossRef]

| Strains | E. coli | Salmonella | S. aureus |
|---|---|---|---|
| LR67 | ++ | ++ | ++ |
| LRA1 | ++ | ++ | ++ |
| LRA10 | ++ | ++ | ++ |
| LRA6 | ++ | ++ | ++ |
| LRA7 | ++ | ++ | ++ |
| LR6 | + | ++ | ++ |
| LR61 | ++ | + | ++ |
| LRA15 | + | ++ | ++ |
| LRA21 | + | ++ | ++ |
| LR8 | + | ++ | ++ |
| LR19 | + | ++ | ++ |
| LR49 | + | ++ | ++ |
| LRG4 | + | ++ | ++ |
| LR2 | + | ++ | ++ |
| LR1 | + | ++ | ++ |
| LRG3 | + | ++ | ++ |
| LR62 | + | + | ++ |
| LRA3 | + | ++ | ++ |
| LR14 | + | ++ | ++ |
| LRG2 | + | + | ++ |
| LRG1 | + | ++ | ++ |
| Items | Results | Items | Results |
|---|---|---|---|
| Glucose | + | Inulin | − |
| Cellobiose | + | Raffinose | + |
| Galactose | + | Hydrogen sulfide test | − |
| Sucrose | + | Sorbitol | − |
| Maltose | − | Aesculin | − |
| Mannitol | − | Hydrogen sulfide test | − |
| Xylose | + | Methyl Red test | − |
| Lactose | + | Voges–Proskauer test | − |
| L-Rhamnose | − | Gelatin liquidized test | − |
| Pectinose | + | Urease test | − |
| Salicin | − | Citrate test | − |
| Motility | − |
| Antimicrobial Classes | Antimicrobial Agents | Disk Dose (μg) | Inhibition Zone Diameters/mm (IZD) a | ||
|---|---|---|---|---|---|
| ≤15 mm (R) | 16–20 mm (I) | ≥21 mm (S) | |||
| β-lactams antibiotics | Penicillin | 10 | 23.17 ± 3.18 S | ||
| Oxacillin | 1 | X R | |||
| Ampicillin | 10 | 19.15 ± 1.53 I | |||
| Piperacillin | 100 | 25.00 ± 1.12 S | |||
| Imipenem | 10 | 30.71 ± 2.83 S | |||
| Aminoglycosides antibiotics | Streptomycin | 10 | X R | ||
| Gentamicin | 10 | X R | |||
| Amikacin | 30 | X R | |||
| Kanamycin | 30 | X R | |||
| Broad-spectrum antibiotics | Tetracycline | 30 | 16.32 ± 2.45 I | ||
| Chloramphenicol | 30 | 22.77 ± 0.68 S | |||
| Minocycline | 30 | 22.70 ± 0.65 S | |||
| Doxycycline | 30 | 20.74 ± 0.92 I | |||
| Cotrimoxazole | 25 | X R | |||
| Macrolides | Azithromycin | 15 | X R | ||
| Erythromycin | 15 | X R | |||
| Clindamycin | 2 | 16.27 ± 1.18 I | |||
| Fluoroquinolone antibiotics | Norfloxacin | 10 | X R | ||
| Ciprofloxacin | 5 | X R | |||
| Levofloxacin | 5 | X R | |||
| Attributes | Values |
|---|---|
| Chromosome size (bp) | 1,974,833 |
| Plasmid size (bp) | 46,076 |
| G + C content of chromosome (%) | 38.86% |
| G + C content of plasmid (%) | 34.33% |
| tRNA | 69 |
| rRNA | 18 |
| Pseudogene numbers | 219 |
| Pseudogene size (bp) | 68,864 |
| CRISPRs | 2 |
| Gene islands | 4 |
| Prophages | 8 |
Disclaimer/Publisher’s Note: The statements, opinions and data contained in all publications are solely those of the individual author(s) and contributor(s) and not of MDPI and/or the editor(s). MDPI and/or the editor(s) disclaim responsibility for any injury to people or property resulting from any ideas, methods, instructions or products referred to in the content. |
© 2024 by the authors. Licensee MDPI, Basel, Switzerland. This article is an open access article distributed under the terms and conditions of the Creative Commons Attribution (CC BY) license (https://creativecommons.org/licenses/by/4.0/).
Share and Cite
Zhang, Y.; Zhao, M.; Li, Y.; Liang, S.; Li, X.; Wu, Y.; Li, G. Potential Probiotic Properties and Complete Genome Analysis of Limosilactobacillus reuteri LRA7 from Dogs. Microorganisms 2024, 12, 1811. https://doi.org/10.3390/microorganisms12091811
Zhang Y, Zhao M, Li Y, Liang S, Li X, Wu Y, Li G. Potential Probiotic Properties and Complete Genome Analysis of Limosilactobacillus reuteri LRA7 from Dogs. Microorganisms. 2024; 12(9):1811. https://doi.org/10.3390/microorganisms12091811
Chicago/Turabian StyleZhang, Yuanyuan, Mengdi Zhao, Yueyao Li, Shuang Liang, Xinkang Li, Yi Wu, and Guangyu Li. 2024. "Potential Probiotic Properties and Complete Genome Analysis of Limosilactobacillus reuteri LRA7 from Dogs" Microorganisms 12, no. 9: 1811. https://doi.org/10.3390/microorganisms12091811
APA StyleZhang, Y., Zhao, M., Li, Y., Liang, S., Li, X., Wu, Y., & Li, G. (2024). Potential Probiotic Properties and Complete Genome Analysis of Limosilactobacillus reuteri LRA7 from Dogs. Microorganisms, 12(9), 1811. https://doi.org/10.3390/microorganisms12091811





